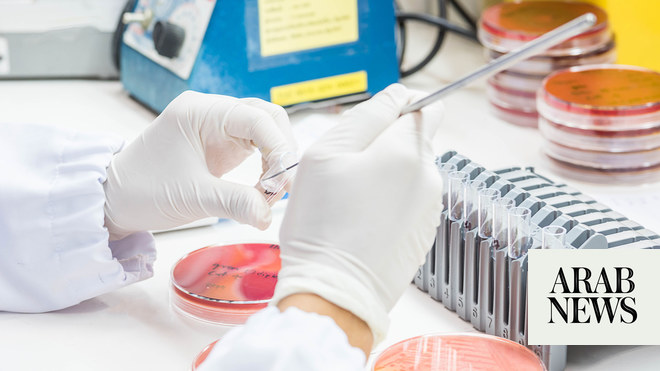

PIFs Lifera Forms JV With Global Omics Diagnostics Firm CENTOGENE
Short Url
https://arab.news/6qjvn
Updated 21 sec ago
Updated 27 June 2023
Updated 27 June 2023
Updated 27 June 2023
Updated 27 June 2023
Updated 27 June 2023
Startup Wrap: MENA Deals Spotlight AI, Expansion, And Strategic Consolidation
RIYADH: Startups across the Middle East and North Africa continue to attract investor interest and pursue strategic expa... Read more
Why Housing And Schooling Benefits Are Becoming Key To Attracting Global Talent To Saudi Arabia
CAIRO: As Saudi Arabia competes globally for highly specialized talent, employers are increasingly recognizing that attr... Read more
Saudi Arabia Gears Up To Export Green Hydrogen
ALKHOBAR: Saudi Arabia is positioning itself as a major exporter of green hydrogen as the world seeks cleaner fuels for ... Read more
Oil Fluctuating As US, Allies Work To Boost Supply, Unchoke Strait Of Hormuz
LONDON: Oil prices swung on Friday as the US outlined moves to manage the supply crisis, while leading European nat... Read more
War Turns Paradise African Island Into Luxury Car Showroom
LAMU, Kenya: Fancy a shiny new Porsche? You could do a lot worse than book a ticket to the paradise island of Lamu off ... Read more
Analysts Warn Of Long-term LNG Market Shift, Dismiss Immediate Supply Crisis Fears
RIYADH: Following QatarEnergy’s announcement that missile strikes have knocked out 17 percent of the country’s lique... Read more






